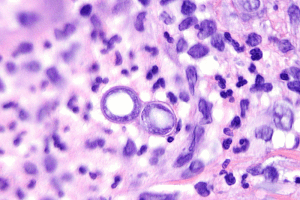
Бластомикоз

Бластомикоз
Добавил пользователь Валентин П. Обновлено: 23.11.2025
Бластомикозом называют группу заболеваний, выражающихся первичными поражениями тканей легких и вторичным поражением грибковой инфекцией через кровяное русло костей, кожи и других органов. Медицинская литература имеет описания нескольких видов бластомикозов, наиболее распространенным из которых является североамериканский тип этого недуга.
Основной причиной североамериканского бластомикоза становится жизнедеятельность особого гриба. Он получил название Blastomyces dermatitidi. Он обитает в почве, а его споры попадают в организм человека при вдыхании, то есть воздушно-пылевым путем. Иногда возможен и половой путь заражения бластомикозом. Распространяется он по организму по лимфатическому или кровяному пути. Гриб этот существует в организме в двух формах: в мицелиальной и в дрожжевой. В последнюю он быстро переходит при повышении температуры организма выше 37 градусов. В такой форме инфекция закрепляется в легких, развивая в них инфильтративные очаги воспаления. В последующем в них формируются некротические и гнойные гранулемы. Кожа и внутренние органы больного заражаются вторично. В них инфекция попадает из легких кровяным руслом.
Данное заболевание встречается у садоводов и огородников, сельскохозяйственных рабочих, проживающих в эндемичных по этому заболеванию районах. Сопутствующие заболевания в виде болезней крови, туберкулеза, сахарного диабета, иммунодефицитов только способствуют развитию такого недуга.
Симптомы и формы недуга
В большинстве случаев, в 60-90%, данное заболевание протекает в легочной форме, как бронхопневмония. Его инкубационный период 1-1,5 месяцев. Начинается остро или подостро с повышения температуры, озноба и суставных болей. Больных начинают беспокоить:
- сухой, а затем сопровожденный кровяной мокротой кашель;
- одышка;
- кровохарканье;
- боли в грудине.
Объективно слышны хрипы, шумы. Рентген дает картину легочных инфильтратов и каверн.
Кожная форма бластомикоза является не часто встречающейся формой этого заболевания. Она проявляется высыпаниями в виде везикул и пустул, которые по мере течения болезни превращаются в язвы с обильным гранулированием. Такие язвы имеют кровянистое или гнойное отделяемое. Процесс течет с образованием подкожных абсцессов, а язвы заживают с образованием мягких рубцов. Нередко язвенные процессы фиксируются в ротовой полости пациентов, в глотке и гортани.
На 25-50% случаев внелегочных форм этого недуга приходится костная форма болезни. Протекает она в виде остеомиелита с поражением позвоночника, ребер, трубчатых длинных костей. Нередко в зоне поражения костей развиваются абсцессы мягких тканей, а к остеомиелитам присоединяются артриты и свищи.
В виде оорхитов, простатита и эпидидимита протекает мочеполовая форма недуга с фиксацией таких симптомов, как гематурия и пиурия. Женщины редко заражаются этой болезнью половым путем и у них она развивается в мочеполовой форме намного реже, чем у мужчин.
Диагностическая программа
В первую очередь бластомикоз следует заподозрить у людей занятых в сельском хозяйстве или прибывших из эндемичных по этой болезни районов. Для постановки диагноза проводят:
- бактериальные посевы мокроты, мочи, ликвора, отделяемого кожных язв, биопсийного материала;
- рентгенографию легких и костей, КТ позвоночника и головного мозга;
- серологические реакции РСК, РИА, ИФА;
Для постановки диагноза требуется консультация пульмонолога, дерматолога, уролога, инфекциониста и миколога.
Лечением недуга является противогрибковая терапия. По показаниям такое лечение может сопровождаться хирургическими вмешательствами.
Своевременность проведения адекватной терапии бластомикозов позволяет добиваться выздоровления в 90% случаев болезни.
Публикации в СМИ
Бластомикоз (болезнь Джилкрайста) — системный (глубокий) микоз, характеризующийся полисистемностью поражения и развитием хронических гнойных гранулём.
Этиология и патогенез • Возбудитель — диморфный гриб Blastomyces dermatitidis; заражение человека происходит при вдыхании спор. Основные пути распространения в организме — гемато- и лимфогенный • Возможно первичное поражение кожи (гематогенное распространение из лёгких без выраженной симптоматики поражения дыхательной системы) • Может передаваться половым путём (бластомикоз органов мочеполовой системы у женщин) • Возникновение бластомикоза возможно при активации латентной инфекции на фоне иммунодефицитных состояний (например, у больных СПИДом).
Факторы риска • Работа с почвой (лица определённых профессий или любители-садоводы), содержащей споры B. dermatitidis • Проживание в местности, эндемичной по бластомикозу.
Клиническая картина
• Острый бластомикоз •• Продолжительность инкубационного периода — 30–45 дней •• Острое или подострое начало •• Возможно бессимптомное течение •• Симптомы интоксикации — повышение температуры тела (чаще субфебрильные значения, хотя возможен и фебрилитет), озноб, миалгии, артралгии •• Кашель (сначала непродуктивный, затем с мокротой), кровохарканье (30%).
• Лёгочный бластомикоз (60–90% всех случаев бластомикоза) •• Симптомы интоксикации •• Кашель (сначала непродуктивный, затем с мокротой), кровохарканье •• Потеря массы тела (в случае хронического течения) •• Плевритические боли (усиливаются на высоте вдоха, при изменении положения тела), одышка •• Сухие и влажные хрипы, шум трения плевры •• В 50% случаев выявляют верхнедолевые очаговые инфильтраты, иногда образуются каверны •• Дыхательная недостаточность развивается редко.
• Кожный бластомикоз (40–80% всех случаев внелёгочных поражений) •• Везикуло-папулёзные высыпания, трансформирующиеся в пустулы и язвы. Выделяют 2 типа кожных высыпаний: ••• Веррукозные — папулёзно-пустулёзные, сливающиеся и покрывающиеся корками; после отторжения последних образуются язвы с обильными бородавчатыми грануляциями, рубцующимся депигментированным центром и микроабсцессами по краям ••• Язвенные — изъязвляющиеся первичные пустулёзные высыпания с образованием мелких язв с приподнятыми краями и гранулирующим дном •• Возможно поражение слизистых оболочек •• Вовлечение регионарных лимфатических узлов (редко) •• Возможно образование подкожных абсцессов.
• Костный бластомикоз (25–50% случаев внелёгочного бластомикоза) — наиболее часто поражаются длинные трубчатые кости, позвонки, рёбра •• Чётко отграниченные очаги остеолиза •• Возможно формирование абсцессов окружающих мягких тканей и/или свищевых ходов. При поражении позвоночника возможны околопозвоночные абсцессы •• Осложнением остеомиелита может стать развитие острого или хронического артрита прилегающих суставов.
• Бластомикоз мочеполовой системы (10–30% случаев внелёгочного бластомикоза) — вовлекаются предстательная железа, а также яички и их придатки •• Возможна обструкция мочевыводящих путей •• Предстательная железа увеличена, болезненна при пальпации •• У женщин заболевание возникает редко (передаётся половым путём).
• Прочие формы бластомикоза •• Поражения ЦНС: острые и хронические менингиты, эпидуральные абсцессы или абсцессы головного мозга •• Возможно поражение печени, селезёнки, перикарда, щитовидной железы, ЖКТ, надпочечников.
Лабораторные исследования требуют привлечения квалифицированного специалиста, т.к. наиболее простой и доступный способ — выявление возбудителя микроскопией лабораторного материала; выделение культуры подтверждает предварительный диагноз. Отбор образцов производят в зависимости от типа и локализации поражений (при любой форме желательно провести биопсию) • Микроскопия: дрожжевые клетки диаметром 5–15 мкм с отпочковывающимися дочерними клетками, лишённые капсулы • Посев материала (биоптаты поражённых мягких тканей, гноя, мочи и т.д.) производят на агар Сабуро и другие обогащённые среды. Через 4 и более недель при 21 °С образуются белые плесневые макроколонии. При 37 °С в течение 7–10 сут образуются кремовато-жёлтые (цвета сливочного масла) колонии • Эффективна реакция радиальной иммунодиффузии; результаты бывают положительными у 80% пациентов уже через 2–3 нед после начала заболевания; реакция имеет специфичность 100% • Кожные аллергические пробы с бластомицином (реакция гиперчувствительности замедленного типа [ГЗТ]) имеют низкие чувствительность и специфичность.
Специальные исследования • Для выявления бластомикоза ЦНС и поражений позвоночника — КТ • Костный бластомикоз диагностируют с помощью остеосцинтиграфии • Рентгенография органов грудной клетки: очаговые инфильтраты в верхних долях лёгких, диффузная альвеолярная инфильтрация, массивные поражения, утолщение плевры • Для диагностики с помощью микроскопии мазков и посева на искусственные питательные среды проводят аспирацию содержимого абсцессов и пункционную или эксцизионную биопсию поражённых тканей.
ЛЕЧЕНИЕ
Тактика ведения • Во всех случаях внелёгочного бластомикоза показана терапия противогрибковыми препаратами • Терапия противогрибковыми препаратами показана также больным лёгочным бластомикозом лёгкой степени и пациентам с невыраженной симптоматикой.
Режим • При остром лёгочном бластомикозе возможно амбулаторное лечение итраконазолом • Лечение больных хроническим бластомикозом, тяжёлой пневмонией, внелёгочными формами бластомикоза осуществляют в стационарных условиях и начинают с в/в введения амфотерицина В.
Оперативное лечение • Иссечение омертвевших участков кости • Дренирование больших кожных абсцессов и плевральной полости в случае эмпиемы плевры.
Лекарственная терапия • При лёгких формах заболевания — итраконазол по 200 мг внутрь 2 р/сут не менее 6 мес или кетоконазол по 400–800 мг внутрь 1 р/сут в течение 6 мес • При тяжёлых формах заболевания — амфотерицин В по 0,5–0,8 мг/кг (не более 50 мг) в 5% р-ре глюкозы в/в капельно в течение 4–6 ч ежедневно до общей дозы 1,5–2,0 г (в первый раз вводят 1 мг препарата в 200 мл 5% р-ра глюкозы в течение 2–4 ч; в дальнейшем дозу увеличивают ежедневно на 10 мг до 0,5–0,8 мг/кг/сут; в тяжёлых случаях полную дозу назначают в 1 или 2 день).
Наблюдение • Необходимы контроль за уровнем электролитов, креатинина сыворотки крови и ОАК 2 р/нед на протяжении всего курса терапии амфотерицином B • После завершения курса лечения врачебный контроль — каждые 3 мес в течение 2 лет; затем — 2 р/год.
Осложнения. Артриты, остеомиелиты, абсцессы головного мозга, побочные реакции амфотерицина В (нарушение функций почек, электролитный дисбаланс, анемия).
Течение и прогноз • При адекватном лечении выздоровление наступает в 90% случаев • Рецидив заболевания возникает менее чем в 10% случаев • При лечении кетоконазолом рецидивы возникают чаще.
Профилактика. Барьерные методы контрацепции (презервативы) при половых контактах со случайными партнёрами.
Бластомикоз
ГБУ РД "Республиканский кожно-венерологический диспансер", Махачкала
Дагестанская государственная медицинская академия, Махачкала
ФГБОУ ВО «Дагестанский государственный медицинский университет» Минздрава России, Махачкала, Россия, 127994
ГБОУ ВПО «Дагестанская государственная медицинская академия» Минздрава России, Махачкала, Россия, 367000
Случай глубокого бластомикоза кожи
Журнал: Клиническая дерматология и венерология. 2018;17(2): 42‑45
ГБУ РД "Республиканский кожно-венерологический диспансер", Махачкала
Представлен анализ данных литературы о бластомикозе кожи, а также собственное наблюдение авторов. В обзоре литературы указаны клинические формы бластомикоза (североамериканский, южноамериканский, келоидный, европейский), при этом подробно рассмотрен североамериканский бластомикоз, возбудителем которого является Blastomyces dermatitidis. Отмечен двухфазный характер манифестации данного возбудителя, что позволяет дифференцировать его с другими патогенными грибами. Указан патогномоничный клинический признак болезни Джилкриста — периферический приподнятый ободок синюшно-бордового или фиолетового цвета, на котором видны мелкие желтоватые точки. В работе приведено наблюдение клинического случая бластомикоза североамериканского у мужчины 51 года. Приведенный клинический случай кожной формы бластомикоза должен напомнить дерматологам клинические особенности, методы микробиологической идентификации возбудителя и помочь в дифференциальной диагностике этой редкой патологии кожи.
ГБУ РД "Республиканский кожно-венерологический диспансер", Махачкала
Дагестанская государственная медицинская академия, Махачкала
ФГБОУ ВО «Дагестанский государственный медицинский университет» Минздрава России, Махачкала, Россия, 127994
ГБОУ ВПО «Дагестанская государственная медицинская академия» Минздрава России, Махачкала, Россия, 367000
В доступной нам литературе описание бластомикоза датируется вплоть до 50-х годов. Мы постараемся напомнить дерматовенерологам особенности этого заболевания и представить случай бластомикоза кожи.
Всю группу больных глубокими микозами объединяют способы заражения (воздушно-пылевой, вследствие травмы), клиническое сходство с различными формами хронических пиодермий, гранулематозных поражений (туберкулез, лепра, третичный сифилис), тяжесть течения и резистентность к терапии.
Бластомикоз встречается в различных клинических формах:
а) бластомикоз североамериканский (болезнь Джилкриста, Гилкриста);
б) бластомикоз южноамериканский (паракокцидиоидоз, паракокцидиоидомикоз, бластомикоз бразильский, болезнь Лутца—Сплендоре—Альмейда);
в) бластомикоз келоидный (болезнь Лобо, бластомикоз Лобо, гленоспороз амазонский);
г) бластомикоз европейский (криптококкоз, торулез, болезнь Буссе—Бушке) [1, 2].
Мы напоминаем о североамериканском бластомикозе, возбудителем которого является Blastomyces dermatitidis. Заболевание впервые было описано Gilchrist в 1894 г., а в 1898 г. была выделена культура гриба [3].
Возбудитель бластомикоза существует в двух формах: дрожжевой (при t 37 °C) и мицелиальной (при t 25 °С). В зависимости от температуры инкубации, по данным C. Arthur [3], форма микроорганизма изменяется. Этот двухфазный характер манифестации гриба позволяет дифференцировать его с другими патогенными грибами (Coccidioidеs immitis, Cryptococcus neoformans), которые в культуре растут только в одной форме.
О форме Blastomyces dermatitidis в тканях и культуре встречаются разноречивые мнения. Так, A. Бушке предполагал, что патогенные бластомицеты размножаются в тканях исключительно почкованием. В то же время А.В. Ильина [4] наблюдала обратное: в культуре имелись лишь типичные бластомицетные клетки в виде круглых или овальных форм, размножавшихся почкованием, тогда как в органах зафиксировано развитие мицелия. Процесс кожного бластомикоза существенно отличался от процесса в органах. В дерме быстро нарастала клеточная реакция, воспалительные явления были резко выражены, а грибы существовали только в виде округлых образований, почкующихся форм, иногда отмечали мицелий или мицелий со спорами.
Мицелиальная форма в культуре имеет толщину мицелия 3—5 мкм с круглыми, овальными, грушевидными кондиями, соединенными с мицелием тонкой ножкой. В старых культурах образуются хламидоспоры [1]. При микробиологической диагностике бластомикоза необходимо учитывать, что довольно часто бластомикоз не дает роста культур [5].
Пути инфицирования человека и источник заражения по настоящее время не установлены. Однако чаще инфицируются работники сельского хозяйства. Заболевание развивается на месте и после травмы кожного покрова, возможен и эндогенный путь поражения кожи при первичном заболевании легких (возбудитель попадает в легкие ингаляторно) [1, 6]. Инкубационный период длится от 1 нед до 4 мес [2]. Поражение кожи начинается с папуло-пустул или подкожных узлов красного цвета и умеренной плотности на открытых участках кожи (лицо, кисти), а также голенях и ягодицах. В течение 2—3 мес медленно увеличиваясь в размерах, первичная эффлоресценция превращается в бляшку диаметром 3—6 см и более. Центр ее представляет собой папилломатозные разрастания, усеянные микроабсцессами желтоватого цвета, богато васкуляризованные, не склонные к ороговению. Неправильные, довольно глубокие щели между сосочками заполнены серозно-гнойным отделяемым [1, 2, 6]. Характерной особенностью является периферический приподнятый и четко отграниченный от нормальной кожи ободок синюшно-бордового или фиолетового цвета, на котором видны мелкие желтоватые точки. Они представляют собой внутриэпидермальные или подэпидермальные микроабсцессы, которые просвечивают через еще неповрежденный роговой слой [6]. При проколе выделяется вязкая кровяная или кровянисто-гнойная жидкость.
Дальнейшая эволюция элементов состоит в их росте по периферии, и одновременно с этим в центре уплощаются вегетации: вместо них появляется влажно-красная гранулирующая и постепенно рубцующаяся поверхность (рубцы мягкие и тонкие) [6]. В таком виде очаг может существовать месяцами и годами. В результате развиваются огромные бляшки (с ладонь и более), рубцующиеся в центре и непрерывно растущие по периферии.
Прогноз при кожной форме бластомикоза благоприятный. Общее состояние организма обычно не нарушено. Больные обычно жалуются на ощущение зуда и жжения в бляшках, чувствительность при надавливании на них. При метастазах во внутренние органы, что наблюдается очень редко, появляются слабость, похудание, лихорадка, кахексия с летальным исходом.
Дифференцируют североамериканский бластомикоз от бородавчатого туберкулеза кожи, лейшманиоза, язвенных и нагноительных заболеваний кожи и подкожной клетчатки, других глубоких микозов (кокцидиоидоз, криптококкоз, хромомикоз, гистоплазмоз).
От веррукозного туберкулеза бластомикоз типа Джилкриста отличается множественностью очагов и наличием изолированных желтоватых микроабсцессов на синюшно-багровом периферическом венчике (последний критерий позволяет исключить и другие глубокие микозы) [6].
Для лейшманиоза кожи, в отличие от бластомикоза, характерно наличие тяжей воспаленных лимфатических сосудов тестоватой консистенции с «четками» вторичных лейшманиом [1]. Точкой опоры служит пребывание в странах эндемичного распространения лейшманиоза и исследование мазков с идентификацией типичных возбудителей лейшмании.
В то же время не нужно отождествлять идентичную бластомикозу клинику с кокцидиоидозом sui generis. Так как 10-летнее изучение этих случаев кокцидиоидоза Т.Г. Сутеевым и соавт. [7] в нашей стране позволило им сделать обоснованный вывод: во всех случаях заболевания, обозначенного как кокцидиоидоз sui generis, Coccidioides immitis не является возбудителем воспалительного процесса в коже. Все эти случаи следует обозначать как гнойный гидраденит. Необходимо учитывать, что возбудитель кокцидиоидоза Coccidioides immitis распространен лишь в эндемичных зонах: в пустынных районах США (Калифорния, Аризона, Техас), в Аргентине, Мексике, Парагвае, странах Африки [1].
В диагностике бластомикоза учитывают клиническую картину, обнаружение возбудителя в мазке и культуре [1].
Для лечения бластомикоза используют амфотерицин В, низорал, орунгал, нистатин, этилйодид; местно — фунгицидные средства; иногда — хирургическое иссечение очагов [1].
Клинический случай
Пациент в возрасте 51 года поступил в кожную клинику ГБУ Републики Дагестан РКВД с жалобами на распространенный очаг поражения и болезненность при надавливании на ягодичную область.
Из анамнеза стало известно, что мужчина болен более 10 лет. Из-за локализации эффлоресценций в интимном месте к врачам не обращался. Лечился самостоятельно, процесс прогрессировал по периферии. В последние годы периодически отмечает общую слабость, недомогание.
Объективно: состояние удовлетворительное. Пациент правильного телосложения, удовлетворительного питания. На коже ягодичной области (cлева и справа) резко выраженный инфильтрат с массивными вегетациями и корочками размером 10×15 см с каждой стороны (рис. 1). Рис. 1. Мощный инфильтрат с вегетациями в области ягодиц. При давлении в положении сидя отмечается болезненность в этой области. В центре выявлены мягкие папилломатозные разрастания с глубокими щелями между сосочками, которые наполнены серозно-гнойным отделяемым (рис. 2). Рис. 2. Папилломатозные разрастания с серозно-гнойным отделяемым из межсосочковых щелей. По периферии очага расположен фиолетовый ободок с мелкими желтыми точками (микроабсцессы). Такие же изолированные элементы наблюдаются и на некоторых сосочках (рис. 3). Рис. 3. Микроабсцессы желтого цвета по периферии и на сосочках очага. За исключением центральной части, вся поверхность бляшки покрыта мягкими тонкими рубцами (рис. 4). Рис. 4. Мягкие тонкие рубцы на поверхности бляшки. Проведена дифференциальная диагностика со следующими заболеваниями — хроническая язвенная пиодермия, глубокие микозы (кокцидиоидоз, бластомикоз), веррукозный туберкулез кожи.
Лабораторные данные. В общем анализе крови — гемоглобин 106 г/л, эритроциты 3,7·10 12 /л, лейкоциты 8,9·10 9 /л (палочкоядерные 0%, сегментоядерные 53%), эозинофилы 3%, базофилы 0%, лимфоциты 39%, моноциты 5%. Общий анализ мочи в пределах нормы. Биохимический анализ крови: глюкоза 5,7 ммоль/л, аланинаминотрансфераза и аспартатаминотрансфераза в норме, тимоловая проба 2,0 ЕД, билирубин общий 8,55 мкммоль/л.
Из отделяемого очага поражения кожи ягодичной области приготовлен препарат, окрашенный по Граму (рис. 5). Рис. 5. Нити мицелия (1) в препарате, приготовленном из отделяемого очага поражения и окрашенном по Граму. В препарате видны нити мицелия, дрожжевые клетки отсутствуют. Проведен также посев гнойного отделяемого на агар Сабуро, который инкубирован при температуре 37 °C. В нем дали рост колонии, которые представляют собой мицелий с круглыми и овальными кондиями на конце нитей. В этой же культуре встречаются единичные дрожжевые формы гриба (рис. 6). Рис. 6. Мицелий (1) с кондиями на конце (2) и дрожжевая клетка (3).
Рентгенография грудной клетки без особенностей. На основании клиники, лабораторных данных и анамнеза был поставлен диагноз бластомикоз кожи (болезнь Джилкриста). Больному проведена терапия, которая еще в стационаре вызвала положительную динамику: аутогемотерапия (№ 8), карсил по 0,35 г 3 раза в день (№ 45), аевит по 1 капсуле 1 раз день (№ 15), доксициклин по 1 капсуле (0,1 г) 2 раза в день (№ 20), нистатин по 0,5 (1 таблетка) 3 раза в день (№ 30), тербинафин по 250 мг 2 раза в день (№ 20), диазолин по 1 таблетке 2 раза в день; местно — смазывание элементов раствором фукорцина.

На фоне лечения выступающие участки несколько запали, отделяемое сохраняется (рис. 7). Рис. 7. Очаг поражения на фоне лечения. Пациент выписан под наблюдение районного дерматолога, на длительный период назначен ламизил по 1 таблетке ежедневно.
В представленном нами случае американского бластомикоза кожи надо отметить, что и в соскобе, и в посеве на агар Сабуро (инкубация при t 37 °C с выделением чистой культуры возбудителя) идентифицирован именно мицелий гриба, а не его дрожжеподобная форма.
Описание подобного наблюдения глубокого микоза — это казуистически редкое явление, которое должно наглядно продемонстрировать дерматовенерологам, врачам общей практики и инфекционистам клинические особенности, методы микробиологической идентификации возбудителя, с целью помочь в дифференциальной диагностике этой редкой патологии кожи.
Бластомикоз Гилкриста. Причины, симптомы и лечение
Бластомикоз Гилкриста – тяжелое хроническое грибковое заболевание легких, кожи, подкожной клетчатки и, по мере генерализации, внутренних органов.
Первое клиническое описание было опубликовано в 1894 году американским дерматологом T.C.Gilchrist (в настоящее время многие авторы, особенно на веб-порталах, считают более грамотным написание «Джилкрайст» – что является ошибкой; на английском языке эта фамилия произносится именно как «Гилкрист»). В медицине употребляются также синонимы «Чикагская болезнь» и «североамериканский бластомикоз», акцентирующие выраженную эндемичность заболевания: диморфный патогенный грибок, вызывающий бластомикоз Гилкриста, наиболее распространен в Северной Америке. Однако в последние десятилетия проблема становится актуальной по всему миру, что было неизбежно в связи с интенсивными миграционными процессами, а также бурным развитием культурного и делового туризма. Североамериканский бластомикоз сегодня диагностируется в Африке, Азии и ряде европейских стран, не исключая и Россию.
2. Причины
Возбудитель – двухфазный грибок Blastomyces dermatitidis, дрожжевая фаза которого является внутритканным паразитом. Присутствие данного патогена, опасного для человека, обнаруживается также в почве, иле, организмах собак, лошадей и кошек. Однако пути передачи и распространения неясны до сих пор.
По одним источникам, риск инфицирования и развития клинической формы бластомикоза повышается при ослаблении иммунитета, однако другие исследования это опровергают. Среди заболевающих преобладают дети. Иногда отмечаются эпидемические вспышки бластомикоза Гилкриста; их причины также не прояснены, однако замечено, что заражение людей и животных происходило, вероятней всего, на берегах лесных рек и ручьев.
Наиболее правдоподобной гипотезой является респираторный путь инфицирования; поражение кожи и других органов в этом случае следует считать вторичным (после поражения бронхолегочной системы).
3. Симптомы и диагностика
До половины всех инфицированных переносят бластомикоз Гилкриста в бессимптомной форме; у таких лиц вырабатывается стойкий иммунитет.
Классическая клиническая картина включает образование гранулем и участков гнойного изъязвления в легких и на коже. Появляется кашель, повышается температура тела (в каждом пятом случае она превышает 38°), больные жалуются на одышку и боли в грудной клетке. В отхаркиваемой мокроте у трети больных присутствует кровь.
При диссеминированной форме поражается ряд внутренних органов, что в тяжелых случаях приводит к летальному исходу.
Наиболее тяжелыми осложнениями являются менингиты и мозговые абсцессы, остеомиелиты и артриты.
Возбудитель идентифицируется либо при микроскопическом анализе образцов гноя, мокроты или пораженной ткани, либо по наличию специфических антител. Кроме того, если симптоматика поражения органов дыхания обычно неспецифична, то глубокий прогрессирующий папилломатозно-язвенный бластомикоз кожи современными врачами должен распознаваться уверенно при клиническом осмотре.
4. Лечение
Острые формы бластомикоза Гилкриста зачастую подавляются иммунной системой и спонтанно разрешаются еще до того, как будет идентифицирован патоген. При хронизации процесса применяют антимикотические препараты (напр., амфотерицин В, кетоконазол). В отсутствие этиопатогенетического лечения процесс быстро генерализуется и в большинстве случаев результирует летально; при поражении центральной нервной системы прогноз наиболее пессимистичен.
В остальных случаях антимикотическая терапия, как правило, эффективна и сопровождается быстрой положительной динамикой.
Бластомикоз
Бластомикоз представляет собой системный микоз – инфекционное заболевание, вызванное болезнетворными грибами и протекающее с поражением легких, кожных покровов и подкожной клетчатки, костной ткани и висцеральных органов.
Причины развития бластомикоза
Возбудитель инфекционного процесса – диморфный сапрофитирующий гриб Blastomyces dermatitidi, обитает в почве. В человеческий организм он проникает при вдыхании грибных спор с частичками пыли. Группу риска составляют рабочие садов и сельских хозяйств, жители эндемичных регионов. Известны случаи заражения при интимных контактах. Развитию заболевания способствуют наличие сахарного диабета, иммунодефицитных состояний, патологий крови, туберкулеза.
Патогенез
Проникнув в ткань легких, грибы провоцируют формирование инфильтративных воспалительных очагов, в которых образовываются гранулемы с некротическими и гнойными массами. Попадание инфекционных возбудителей в кровяное русло, способствует поражению кожи, костей, центральной нервной системы и внутренних органов – печени, селезенки, мочеполового тракта, щитовидной и надпочечных желез.
Симптомы бластомикоза
Инкубационный период длится около 40 дней. Инфекционный процесс развивается остро – у пациентов наблюдаются признаки интоксикации, высокая температура тела, миалгия, озноб, артралгия, кашель, одышка, болезненные ощущения в грудине.
Прогрессирование заболевания сопровождается:
- появлением везикуло-папулезной сыпи, из которой формируются участки изъязвления с обильной грануляцией;
- развитием артритов и остеомиелита;
- образованием абсцессов мягких тканей;
- поражением мочеполовой системы;
- надпочечниковой недостаточностью;
- возникновением перикардита, менингита, абсцессов печени и головного мозга.
Диагностика
Дифференциальное диагностирование бластомикоза с туберкулезом, бактериальной пневмонией, сифилисом, эмпиемой плевры, абсцессом легких, легочной формой аспергиллеза, дерматомикозами и бактериальным остеомиелитом основано на результатах:
- Сбора личного и эпидемиологического анамнеза.
- Физикального осмотра пациента.
- Консультаций врачей: инфекциониста, пульмонолога, уролога, миколога, дерматолога.
- Кожных аллергических тестов.
- Рентгенографии органов грудной клетки.
- Компьютерной томографии позвоночного столба и головного мозга.
- Ультрасонографии брюшных органов.
- Остеосцинтиграфии.
- Бактериологических посевов и микроскопических анализов мокроты, мочи, ликвора, отделяемого абсцессов и свищей, биопсийного материала, позволяющих обнаружить наличие Blastomyces dermatitidi. – для обнаружения специфических антител, направленных на борьбу с антигенами инфекционного агента.
Лечение
Пациентам с бластомикозом проводят противогрибковую терапию с применением Кетоконазола, Итраконазола, Амфотерицина В. При необходимости выполняют вскрытие абсцессов, дренирование плевральной полости, некр-эктомию и другое хирургическое лечение.
Чтобы предотвратить инфицирование B. dermatitidi необходимо соблюдать правила личной гигиены, надевать защитные средства при сельскохозяйственных работах, использовать барьерные средства контрацепции.
Россия, Краснодарский край,
г. Сочи, ул. Старонасыпная, 22.
Размещенная на сайте информация и прейскурант не являются публичной офертой.
Читайте также:
